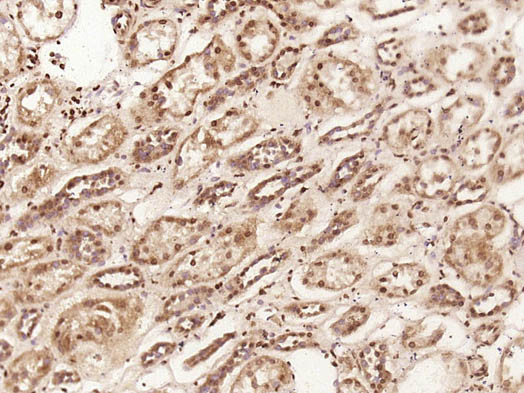
C1orf200 Antibody in Immunohistochemistry (Paraffin) (IHC (P))

Search
Bioss
C1orf200 Polyclonal Antibody
{{$productOrderCtrl.translations['antibody.pdp.commerceCard.promotion.promotions']}}
{{$productOrderCtrl.translations['antibody.pdp.commerceCard.promotion.viewpromo']}}
{{$productOrderCtrl.translations['antibody.pdp.commerceCard.promotion.promocode']}}: {{promo.promoCode}} {{promo.promoTitle}} {{promo.promoDescription}}. {{$productOrderCtrl.translations['antibody.pdp.commerceCard.promotion.learnmore']}}
Additional Information:
{{banner.description}}
图: 1 / 2
C1orf200 Antibody (BS-15055R) in IHC (P)
Paraformaldehyde-fixed, paraffin embedded human kidney; Antigen retrieval by boiling in sodium citrate buffer (pH6) for 15min; Block endogenous peroxidase by 3% hydrogen peroxide for 30 minutes; Blocking buffer (normal goat serum) at 37°C for 20min; Antibody incubation with C1orf200 Polyclonal Antibody, Unconjugated (bs-15055R) at 1:200 overnight at 4°C, followed by a conjugated secondary and DAB staining.


产品信息
BS-15055R
应用
建议稀释比
已发表文章
产品规格
种属反应
Human,
Rat
宿主/亚型
Rabbit
/ IgG
分类
Polyclonal
类型
Antibody
抗原
KLH conjugated synthetic peptide derived from human C1orf200.
偶联物
Unconjugated
Unconjugated
Unconjugated
形式
Liquid
浓度
1 mg/mL
规格
100 µg
纯化类型
Protein A
保存液
0.01M TBS, pH 7.4, with 50% glycerol, 1% BSA
内含物
0.02% ProClin 300
保存条件
-20°C
运输条件
Ambient (domestic); Wet ice (international)
靶标信息
PIK3CD-AS1 (PIK3CD Antisense RNA 1) is an RNA Gene, and is affiliated with the lncRNA class.
仅用于科研。不用于诊断过程。未经明确授权不得转售。
篇参考文献 (0)
您是否在文献中引用过该产品?请点击下方按钮邮件告知我们。